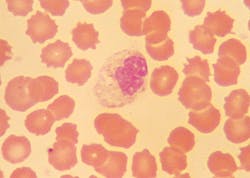
Mlo201707 Ce Story Hawaii Fig1 Mlo201707 Ce Story Hawaii Fig1

EDTA in transit: degenerative changes in blood cell morphology
Today, more tests than ever are being performed at facilities that are remote from where the samples are collected. More than 70 percent of patient care is now being delivered outside of the hospital setting, at venues where immediate laboratory services may not be available.1
As the number of outpatient visits continues to increase, some hospitals are also incorporating “lab outreach” businesses for greater efficiency and economy. Laboratories are now receiving samples from remote sites two or more days after venipuncture.2 Thus, maintaining sample integrity during transport is a crucial issue for receiving laboratories. Delays in testing and improper packaging can result in degenerative changes that contribute to serious errors and untrustworthy results.
The complete blood count (CBC) remains one of the most frequently requested laboratory tests, used to screen for a wide variety of conditions. Automated analyzers are used to count cells, measure hemoglobin levels, and calculate parameters such as the hematocrit and erythrocyte indices. They also produce erythrocyte distribution histograms and data plots showing leukocyte population clusters. Some “high tech” analyzers can even fully differentiate various types of leukocytes, although most laboratories perform microscopic analyses, especially when instrumental data indicate presence of abnormalities.
Blood cells in an anticoagulated sample will undergo degenerative changes over time. Altered results in leukocyte differential counts and microscopic morphology due to testing delay are not only erroneous, but may cause misinterpretation with potentially harmful consequences.
Changes in aging samples
With samples that are collected in ethylene diamine tetraacetate (EDTA) and kept at room temperature, CBC data generated by automated instruments can remain relatively unchanged for a few days.2,3 Over time, however, significant changes in relative and absolute numbers of neutrophils, lymphocytes, and other components of the blood occur. Eosinophil counts, which are typically low, can vary over time as well.
In comparison, changes that can be seen under a microscope, such as chromatin degradation and cytoplasmic fragmentation in leukocytes, and erythrocyte deformations, can occur in just one day. Minor changes could be seen as early as within 30 minutes of venipuncture.4-6 For this reason, it is recommended that smears for microscopic analyses be prepared within two to three hours of blood collection, preferably within an hour.7
Our study and results
As a class project at the University of Hawaii (with consent of participants), we tracked changes in microscopic leukocyte differential counts and cellular morphology in an EDTA sample that was kept at room temperature. Each day, up to day-6 of venipuncture, blood smears were prepared from the EDTA sample by wedge technique and stained with a commercial Wright stain. Smears were then randomly coded to “blind” the analysts who performed the standard microscopic differential counts.
On the smears made from day-2 EDTA sample, alterations in leukocyte and erythrocyte morphology were already evident; they were more pronounced on smears made on subsequent days. By day-4 of sample collection, damage to the cells were so severe that a meaningful differential count was no longer possible.
A Z-test for proportions at 0.05 level of significance showed that the increase in the proportion of degenerated neutrophils and the decrease in the proportion of segmented neutrophils were both statistically significant on day-2. The proportion of band neutrophils degreased to a significant level on day-4. The average number of platelets seen under the oil immersion magnification (×1000) dropped to about 50 percent on day-2. (Table 1)
Morphological changes in leukocytes were most obvious with granulocytes. Degenerative changes include cytoplasmic rupture, loss of nuclear shape, elongation or indistinct segmentation of granulocyte nuclei, loss of chromatin definition (appear to have liquefied), pyknotic nuclei (necrobiotic forms), degranulation and cytoplasmic vacuolation. (Figures 1, 2) Also on day-2, erythrocytes began to show poikilocytosis with crenated forms and cytoplasmic spikes (burr cells, echinocytes). (Table 2)
In contrast, no change in morphology, differential counts or average platelet numbers per oil immersion field was seen on smears prepared on day-1 of venipuncture but stained five days later.
Implications for remote collection
In as little as one day after the venipuncture, the sample collected in EDTA and kept at room temperature began to show significant degenerative changes in leukocyte and erythrocyte morphology. By day-4, changes were so severe that no clinical laboratory would accept such a sample for testing.
Without the knowledge of precise specimen collection time, changes that occur due to delay in smear making could be misinterpreted. For example, if degenerating non-segmented neutrophils were misidentified as young neutrophils (bands and metamyelocytes), the differential count would appear to show a “left shift.” Together with vacuolations in the cytoplasm, the smear may be incorrectly interpreted as “toxic,” a sign of bacterial infection. Crenated erythrocytes can also resemble acanthocytes that are associated with certain lipid disorders.
For automated CBC, EDTA samples that are one or two days old may provide acceptable data, possibly longer if kept at 4°C. But smears made from samples that are more than a day old cannot be used for microscopic analyses.
As the consolidation of laboratory services continues and more samples are transported from remote collection sites, compounded by a chronic workforce shortage, testing delay may be inevitable. However, in order to avoid erroneous reports in CBC caused by the time lapse, the following recommendations are made to the laboratory community:
- Samples in EDTA should be transported to the lab as soon as possible, preferably tested within a day of venipuncture.
- For automated CBC, EDTA sample may be kept at room temperature; keeping at 4°C may preserve the sample longer, but this may induce other problems such as cold agglutination.
- Well-made blood smears should be prepared immediately after the venipuncture, and should accompany the EDTA sample to the laboratory.
- All specimens and smears must be completely labeled with appropriate identifiers.
- If the blood smear is not made within one hour of venipuncture, date and time of smear preparation should be noted.
REFERENCES
- Giuma J. Outreach 2.0: How times have changed. MLO. 2016;48(9):33.
- Hedberg P, Lehto T. Aging stability of complete blood count and white blood cell differential parameters analyzed by Abbott CELL-DYN Sapphire hematology analyzer. Int J Lab Hem. 2008;31(1):87-96.
- Gulati GL, Hyland LJ, Kocher W, Schwarting R. Changes in automated complete blood cell count and differential leukocyte count results induced by storage of blood at room temperature. Arch Pathol Lab Med. 2002;126(3):336-342.
- Vives-Corrons JL, Briggs C, Simon-Lopez R, et al. Effect of EDTA-anticoagulated whole blood storage on cell morphology examination. A need for standardization.
(Letter to the Editor). Int J Lab Hem. 2013;36(2):222-226. - Weekx S, Vermeiren S, Ver Elst K. EDTA-anticoagulated whole-blood storage: need for a diagnostic driven standardization (Letter to the Editor). Int J Lab Hem. 2014;37(3):426-427.
- Kennedy JB, Maehara KT, Baker AM. Cell and platelet stability in disodium and
tripotassium EDTA. Am J Med Technol. 1981;47(2):87-93. - Rodak BF, Fritsma GA, Keohane EM. Hematology: Clinical Principles and
Applications (4th ed.). St. Louis, MO. Elsevier-Saunders; 2012:193.
Dick Y. Teshima, MPH, MT(ASCP), is an associate professor and program chair at the University of Hawaii at Manoa, John A. Burns School of Medicine, Medical Technology program, in Honolulu. In preparing this article, he was assisted by his students Nikolas Butrick, Andrea Cadelina, Youngeun Choi, Wang Lio, Jennifer Lum, and Amber Tarango.